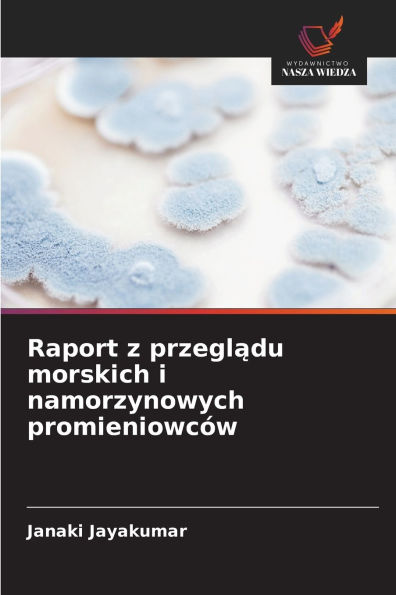
Raport z przeglądu morskich i namorzynowych promieniowcÃ¯Â¿Â½w

Home
Mediacja i rozstrzyganie spor�w z osobami z zaburzeniami funkcji poznawczych
Barnes and Noble
Loading Inventory...
Mediacja i rozstrzyganie spor�w z osobami z zaburzeniami funkcji poznawczych in Chattanooga, TN
Current price: $35.00

Barnes and Noble
Mediacja i rozstrzyganie spor�w z osobami z zaburzeniami funkcji poznawczych in Chattanooga, TN
Current price: $35.00
Loading Inventory...
Size: OS
Książka ta daje wgląd w pionierską pracę w zakresie mediacji i rozstrzygania sporów z osobami z zaburzeniami funkcji poznawczych. Porusza ona kwestie wykonalności i zasadności, a także nawiązuje do teorii i praktyki mediacji. Na podstawie doświadczeń mediacyjnych sprawdzono, czy i w jakiej formie mediacja nadaje się jako narzędzie rozwiązywania konfliktów z osobami z zaburzeniami funkcji poznawczych. Ponadto przedstawiono model rozstrzygania sporów, w którym osoby z zaburzeniami funkcji poznawczych są szkolone jako mediatorzy, a specjaliści stają się ich asystentami. Zgodnie z mottem "kto potrafi się klócic, potrafi też mediowac". W drugiej części książki przedstawiono kamienie milowe w pracy mediatorów i mediatorów sporów od 2005 roku do dziś. Aspekty mediacji są odnoszone do konwencji ONZ dotyczących praw osób niepelnosprawnych oraz aktualnych koncepcji dzialania. Uwzględniono różnorodne doświadczenia praktyczne związane z mediacjami, rozstrzyganiem sporów, konferencjami specjalistycznymi i szkoleniami zespolów mediatorów, które potwierdzają obecną praktykę mediacyjną opartą na wzmacnianiu pozycji i partycypacji.
Książka ta daje wgląd w pionierską pracę w zakresie mediacji i rozstrzygania sporów z osobami z zaburzeniami funkcji poznawczych. Porusza ona kwestie wykonalności i zasadności, a także nawiązuje do teorii i praktyki mediacji. Na podstawie doświadczeń mediacyjnych sprawdzono, czy i w jakiej formie mediacja nadaje się jako narzędzie rozwiązywania konfliktów z osobami z zaburzeniami funkcji poznawczych. Ponadto przedstawiono model rozstrzygania sporów, w którym osoby z zaburzeniami funkcji poznawczych są szkolone jako mediatorzy, a specjaliści stają się ich asystentami. Zgodnie z mottem "kto potrafi się klócic, potrafi też mediowac". W drugiej części książki przedstawiono kamienie milowe w pracy mediatorów i mediatorów sporów od 2005 roku do dziś. Aspekty mediacji są odnoszone do konwencji ONZ dotyczących praw osób niepelnosprawnych oraz aktualnych koncepcji dzialania. Uwzględniono różnorodne doświadczenia praktyczne związane z mediacjami, rozstrzyganiem sporów, konferencjami specjalistycznymi i szkoleniami zespolów mediatorów, które potwierdzają obecną praktykę mediacyjną opartą na wzmacnianiu pozycji i partycypacji.